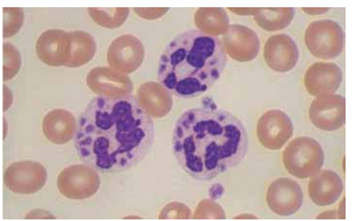
Enunciado 4918614-1

Foram encontradas 50 questões.
JRC, 20 anos, que deu entrada na Unidade Básica de
Saúde com quadro de dispneia aos pequenos esforços,
astenia e indisposição em um período de 4 meses.
Paciente relatou aparecimento de petéquias por todo
o corpo, gengivorragia e hematomas em membros
superiores sem traumas desencadeantes. Negou uso
de drogas, cigarro, bebida alcoólica, comorbidades, uso
de medicações contínuas e antecedentes familiares.
Hemograma com hemoglobina 10,5 g/dL; leucograma
1.730/mm3
, com predomínio de linfócitos 90,3%; plaquetas 23.000/mm3
, reticulócitos 20.000/mm3
e sorologias para HIV, hepatite B e C negativas. Biópsia de
medula 25% celularidade compatível com aplasia de
medula.
Os achados configuram anemia aplásica
Os achados configuram anemia aplásica
Provas
Questão presente nas seguintes provas
Masculino, 57 anos, com diagnóstico de carcinoma
urotelial invasivo de bexiga e indicação de cistectomia
radical Internado para cuidados pré-operatórios, iniciando tromboprofilaxia com heparina não fracionada.
No 5o PO, evoluiu com TEP em ramo subsegmentar
de artéria pulmonar esquerda, Iniciada dose terapêutica da HBPM, sem necessidade de trombólise. No
12o PO, iniciou quadro de trombocitopenia grave (plaquetas 18.000/mm3), refratária às transfusões plaquetárias.
Em relação a esse quadro, é correto afirmar:
Em relação a esse quadro, é correto afirmar:
Provas
Questão presente nas seguintes provas
De acordo com os critérios estabelecidos pelo Grupo
de Trabalho Internacional de Mieloma (IMWG-2016),
caracteriza recaída clínica:
Provas
Questão presente nas seguintes provas
A síndrome hipereosinofílica idiopática (SHI) é uma
doença caracterizada por eosinofilia persistente idiopática, associada à infiltração eosinofílica dos tecidos.
Em relação a ela, é correto afirmar:
Em relação a ela, é correto afirmar:
Provas
Questão presente nas seguintes provas
Observe a imagem a seguir:
(Arquivo pessoal; imagem usada com autorização)
A imagem pode ser observada na
Provas
Questão presente nas seguintes provas
Na SAF, também conhecida como síndrome do anticorpo
antifosfolipídeo, é correto afirmar:
Provas
Questão presente nas seguintes provas
No que diz respeito às doenças de membrana eritrocitária, é correto afirmar:
Provas
Questão presente nas seguintes provas
Talassemias são hemoglobinopatias quantitativas, hereditárias, genéticas, decorrentes de mutações, na maioria
dos casos, nos genes das globinas alfa ou beta, que promovem a redução ou a ausência de síntese de uma ou
mais cadeias de globina formadoras da hemoglobina.
Em relação a elas, é correto afirmar:
Em relação a elas, é correto afirmar:
Provas
Questão presente nas seguintes provas
Em relação aos linfomas cutâneos de células T (LCCT),
é correto afirmar:
Provas
Questão presente nas seguintes provas
A trombofilia pode ocorrer por mutações ou deficiências na produção dos fatores de coagulação e pode ser
hereditária ou adquirida. As trombofilias hereditárias
constituem um grupo heterogêneo de alterações na
coagulação sanguínea, que aumentam a predisposição
ao desenvolvimento de fenômenos tromboembólicos e
manifestam-se, em geral, na presença de outros fatores de risco.
Em relação às trombofilias, é correto afirmar:
Em relação às trombofilias, é correto afirmar:
Provas
Questão presente nas seguintes provas
Cadernos
Caderno Container